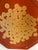
Mid-Century Modern Vintage MCM Eight Sided Laquered Tray For Sale - Image 3 of 6

Details
Description
Cute little eight sided octagonal tray with a Japanese design. Cute little eight sided octagonal tray with a Japanese design.
- Dimensions
- 9.25ʺW × 9.25ʺD × 0.5ʺH
- Period
- Mid 20th Century
- Item Type
- Vintage, Antique or Pre-owned
- Materials
- Plastic
- Condition
- Good Condition, Original Condition Unaltered, Some Imperfections
- Color
- Orange
- Condition Notes
- Good condition with some wear Good condition with some wear less
Questions about the item?
Returns & Cancellations
Return Policy - All sales are final 48 hours after delivery, unless otherwise specified in the description of the product.
Cancellation Policy - Prior to shipping or local pickup, buyers may cancel an order for up to 48 hours, unless otherwise specified.
Related Collections
- Gustavsberg Trays
- Chrome Finish Trays
- Chase Brass and Copper Company Trays
- Virginia Metalcrafters Trays
- Willy Rizzo Trays
- Louis XV Trays
- Le Corbusier Trays
- Emilia Castillo Trays
- Polished Copper Finish Trays
- Coral Trays
- Venini Trays
- Barovier and Toso Trays
- Bone China Trays
- Terra Cotta Trays
- Maison Baguès Trays
- Los Castillo Trays
- Seagrass Trays
- Copper Trays
- Silver Trays
- Brass Trays
- Persian Trays
- Silverplate Trays
- Georges Briard Trays
- Mid-Century Modern Trays
- Metal Trays